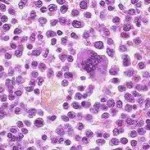
BM

Acupuncture For Spinal Cord Injury
New breakthrough research may be changing the outcomes of spinal cord injuries. This new study discovered that implanted electro-acupuncture combined with bone marrow transplants increases success rates in the healing of spinal cord injuries.
Previously, bone marrow cells were injected into the spinal cord to help increase motor (movement) ability. Unfortunately, the survival rates of these injected cells is generally very low clearly limiting the effectiveness of the procedure.
Scientists in this study, combined electro-acupuncture with the cell injections and concluded that electro-acupuncture created a higher functional improvement in motor function compared to cell injection alone. They also concluded that more of the cells survived the procedure when using electro-acupuncture.
The researchers concluded that “our experiment showed that the approach of coupling iEA (implanted electro-acupuncture) electric stimulation and BMSCs transplantation remarkably promotes functional improvements in animals with spinal cord injury and holds promising potential to treat spinal cord injury in humans.”
You can read the entire article here:
http://www.healthcmi.com/index.php/acupuncturist-news-online/561-acupunctureceusspinalparalysis